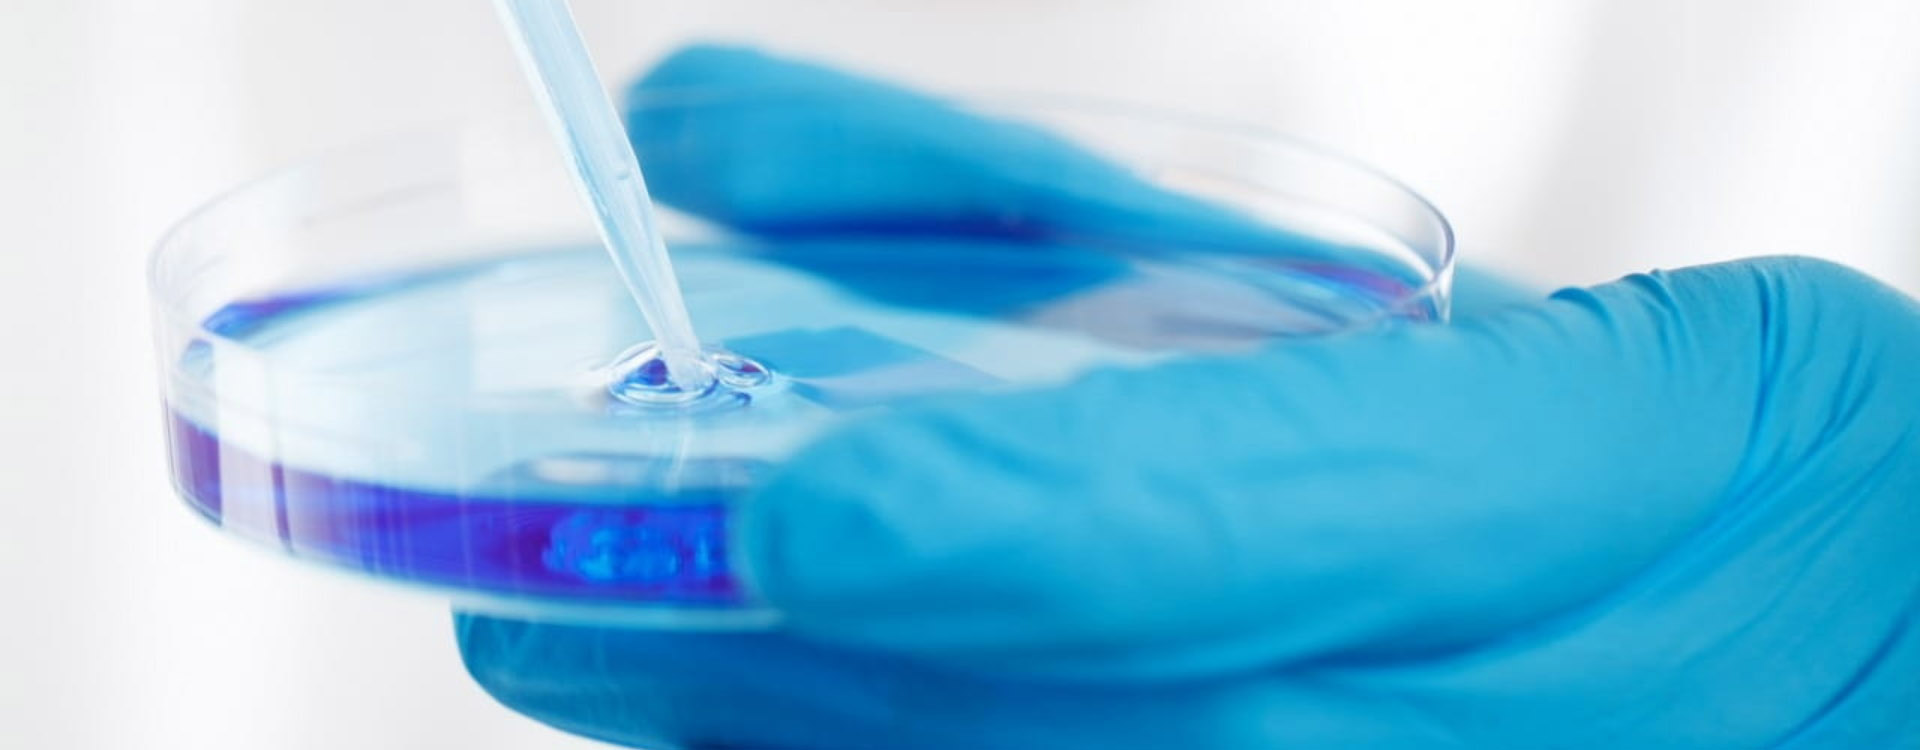
banner2

-
?
- 網站首頁
- 關于鼎皓
公司概況 企業文化 人才招聘 銷售網絡
about us
關于山東鼎皓生物山東鼎皓生物科技有限公司是一家從事生物制品、原料藥、醫藥中間體、精細化學品的生產與銷售、技術研發與服務的企業..
- 新聞中心
- 產品展示
精細化工人用醫藥中間體人用原料藥獸用原料藥&中間體其他
Products
產品類別山東鼎皓生物科技有限公司是一家從事生物制品、原料藥、醫藥中間體、精細化學品的生產與銷售、技術研發與服務的高新技術企業..
- 聯系我們
- ENGLISH